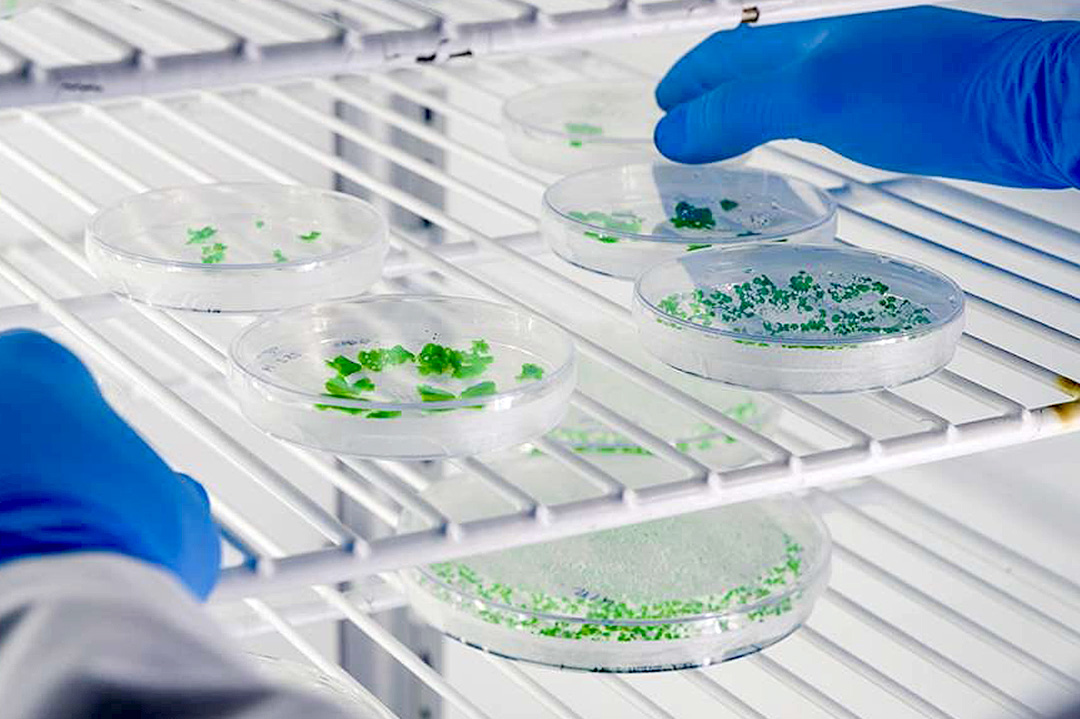

Pharmaceuticals & Healthcare Logistics
NAF Pharma delivers tailored pharmaceutical and healthcare logistics with compliant documentation, reliable handling, and on-time delivery. We protect product integrity throughout the supply chain, including temperature-sensitive shipments and critical, time-sensitive transport needs.
NAF Pharma Delivering Solutions Ensuring Compliance for Healthcare Shipments
Pharma cargo is temperature-sensitive, time-critical, and deeply personal. Someone's treatment. Someone's clinical trial. We built NAF Pharma as a dedicated division because this cargo demands a different standard: GDP-certified facilities, validated packaging, and a team that knows the gap between 2-8°C and ambient can determine whether a shipment arrives usable or gets destroyed.

A Dedicated Pharma Division
We didn't add pharma to a general freight operation. We built a separate division with its own SOPs, its own warehouse protocols, and its own trained team. GDP certified. ISO 9001. Temperature mapping on every facility.
The reason is simple: a blood sample at-75°C with a UN3373 classification needs a fundamentally different level of care than standard cargo. Our pharma team knows that, and they operate accordingly.

Temperature Controlled Shipping
Service
2-8°C, 15-25°C, -20°C, -75°C. We match the packaging, routing, and carrier to your product's stability requirements. Every lane validated before the first shipment moves.

Storage and Distribution
GDP-certified warehousing with temperature-mapped zones. Quarantine areas, controlled access, and batch-level traceability from receipt to dispatch.

Temperature & Humidity Monitoring
Data loggers on every shipment. Real-time alerts if conditions deviate. Full chain-of-custody documentation ready for regulatory audits at any point.

Passive and Active Packaging Solutions
Validated thermal packaging for every temperature range. We assess your product profile and recommend the right solution. Over-packaging costs money. Under-packaging costs product.

Third-Party Logistics (3PL)
Pick, pack, and ship under GDP conditions. Serialization and batch tracking with expiry management built in. We handle the operational complexity so your team focuses on patients.

Control Tower
Single point of visibility across your pharma supply chain. Temperature alerts and milestone tracking with exception management in one dashboard, covering every shipment.
Expertly Delivered Specialist Healthcare Solutions for Critical Medical Shipments.
NAF Pharma provides expertly managed healthcare logistics for critical medical shipments—specialized handling, compliant documentation, cold-chain reliability, and timely delivery to protect patient safety worldwide.